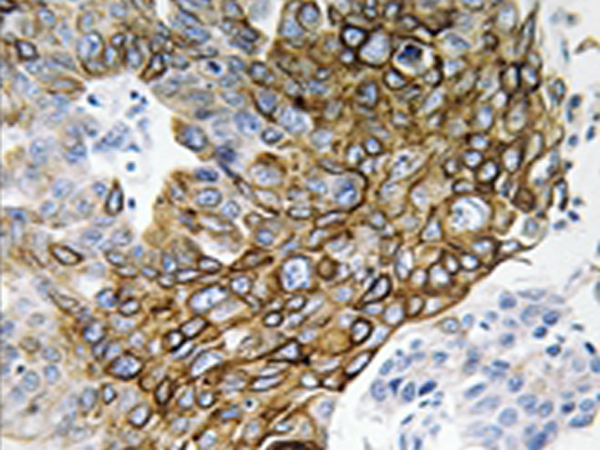
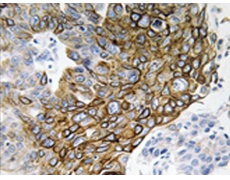
一抗

|
Background: |
The protein encoded by this gene is a connexin and is a component of lens fiber gap junctions. Defects in this gene are a cause of zonular pulverulent cataract type 3 (CZP3). |
|
Applications: |
IHC |
|
Name of antibody: |
GJA3 |
|
Immunogen: |
Synthesized peptide derived from internal of human GJA3. |
|
Full name: |
gap junction protein, alpha 3, 46kDa |
|
Synonyms: |
CX46; CZP3; CTRCT14 |
|
SwissProt: |
Q9Y6H8 |
|
IHC positive control: |
Human lung carcinoma tissue |
|
IHC Recommend dilution: |
50-100 |
購(gòu)物車
購(gòu)物車 幫助
幫助
 021-54845833/15800441009
021-54845833/15800441009